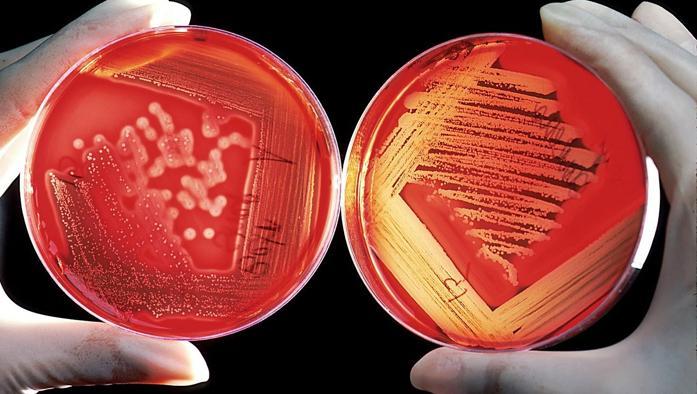
intestino

Incidente in A/1 : un morto e sedici feriti.La tratta autostradale interessata è rimasta chiusa dalle 3 alle 7 di questa mattina
Un grave incidente si è verificato alle due di questa notte al km 632 sud dell’autostrada A/1 nel territorio del Comune di Arnara
[...]